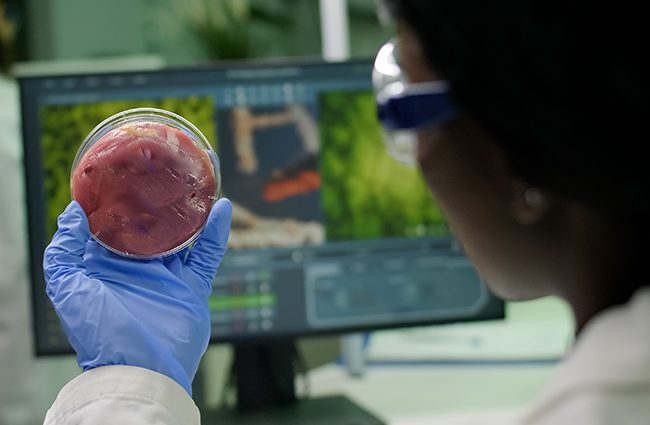

Il “compleanno” del nostro pianeta è il 22 aprile, un giorno speciale per imparare a proteggere la nostra terra. Quando è nata la giornata della Terra? Nata nel 1979 dopo un grave Stefania Fanucci ...
Il 22 marzo è la Giornata mondiale dell’acqua istituita nel 1992 dalle Nazioni Unite. Perché si festeggia l’acqua? Perché è un bene prezioso per tutti, grandi e piccoli. L’acqua è Stefania Fanucci ...
Lo spogomi è una gara sportiva giapponese nata nel 2008 che unisce l’attività sportiva alla difesa dell’ambiente con la raccolta dei rifiuti per le strade. La parola nasce dall’unione tra Stefania Fanucci ...
L’Organizzazione delle Nazioni Unite lancia l’allarme per la scarsità di acqua in tutto il mondo. In molti paesi, infatti, si consumano e inquinano più risorse idriche da fiumi, laghi, falde e ghiacciai di quelle che il pianeta riesce a rigenerare. ...
Probabilmente sono estinte da tempo ma ora lo sono ufficialmente. Come ogni anno l’IUCN (Unione Internazionale per la Conservazione della Natura) ha aggiornato la lista rossa delle specie scomparse. Che cos’è l’IUCN? È come un grande Stefania Fanucci ...
È un grande incontro dove i capi di 198 Paesi si riuniscono per parlare di come proteggere la Terra e prendere decisioni importanti sul cambiamento climatico cioè sul riscaldamento del Pianeta causato Stefania Fanucci ...
Il miele è apprezzato per la sua dolcezza e come emolliente per la gola quando il freddo arriva e i malanni di stagione pure. Pochi sanno che è anche un ottimo misuratore dell’inquinamento. L’idea di sfruttare il miele per stabilire ...
Il ghiacciaio della Marmolada, simbolo delle Dolomiti, continua a ritirarsi e, secondo il Museo di Geografia dell’università di Padova, entro il 2050 sarà fuso. Quest’anno è arretrato ancora sette metri e nei punti più sottili il ghiacciaio è arretrato anche ...
Sui nuovi modelli smartphone e tablet è apparsa, da qualche giorno, una etichetta energetica. È simile a quella che si trova già sui frigoriferi e televisori ed è stata introdotta dal 20 giugno da un nuovo regolamento dell’Unione Europea. È ...
In estate l’effetto serra causa ondate di calore sempre più intense, frequenti e prolungate, con grande disagio per tutti. I disagi delle ondate di caldo sono ancora più forti nelle città, dove il Stefania Fanucci ...
Il 5 febbraio è la giornata nazionale dedicata alla prevenzione dello spreco alimentare, istituita nel 2014 dal Ministero dell’Ambiente. Cosa significa spreco alimentare? Per “spreco alimentare” si intende Stefania Fanucci ...
L’EOD (earth overshoot day) è il giorno del superamento terrestre che significa che è il giorno in cui l’umanità ha consumato tutte le risorse naturali che il pianeta può produrre nell’intero anno. Nell’anno 2024 questo giorno è stato il Stefania ...
Il 2024 è l’anno più caldo di sempre. La temperatura mondiale è aumentata di un grado e mezzo rispetto al 1850. È la prima volta ed è necessario che si trovino dei rimedi. Come si fa a calcolare l’aumento della ...
Il più grande ghiacciaio francese con i suoi 1913 metri, la “Mer de Glace” di Chamonix, si sta sciogliendo a ritmo sostenuto. Dal 1850 ha perso 300 metri di spessore, solo negli ultimi due anni la perdita è stata di ...
Ci sono alcuni animali che non hanno una vita semplice. Un po’ per responsabilità dell’uomo e un po’ perché il loro ambiente sta cambiando questi nostri amici rischiano di scomparire. Conosciamoli, così impareremo a Stefania Fanucci ...
I fenomeni atmosferici estremi che si sono verificati in questi giorni al Nord e hanno colpito con nubifragi e inondazioni le regioni del Piemonte e della Valle D’Aosta sono in contrasto con il calore e la siccità delle regioni del ...
Il mare Mediterraneo ospita una straordinaria varietà di vita marina per essere solo una minima parte di acqua salata sulla Terra. In questo mare si contano oltre 17mila specie diverse: tra queste ci sono le tartarughe marine la cui giornata ...
Clima, ossigeno, biodiversità, bellezza: la salute del mare è indispensabile per un futuro sostenibile della Terra. Gli esperti lo sanno: per questo nel 1992 a Rio de Janeiro, durante una conferenza sull’ambiente, è stata istituita la Gionata mondiale degli Oceani ...
Quando si parla di cambiamenti climatici, bisogna sempre aspettarsi qualche sorpresa, raramente positiva. Lo sai bene che il riscaldamento globale ha effetti gravissimi su coloro che vi sono esposti e, strano ma vero, proprio iPaesi che inquinano meno ne subiscono ...
Nel corso del Novecento molte persone credevano che il futuro sarebbe stato sempre migliore. Nonostante la distruzione portata da due guerre mondiali, nonostante le difficili condizioni in cui vivevano le persone, si pensava che l Stefania Fanucci ...
Avrai sentito parlare da giorni dell’inquinamento atmosferico e delle polveri sottili che fanno male a tutti. Alcune città hanno preso dei provvedimenti imponendo l’abbassamento dei riscaldamenti e il divieto di circolare per alcune macchine. Cosa sono le polveri sottili? Sono ...
La legge, in Italia, non è stata ancora approvata ma è nuovamente oggetto di discussione ed è probabile che, tra non molto, ci sarà un nuovo divieto: nessuno potrà importare o produrre la carne sintetica, coltivata in laboratorio dalle cellule ...
Dubai, negli Emirati Arabi Uniti, dalla fine di novembre a metà dicembre, ospita la Cop28, la conferenza delle Nazioni Unite sui cambiamenti climatici. Che cosa significa Cop? Cop, conferenza delle parti, è un Stefania Fanucci Immagine by Freepik ...
Siamo campioni europei di economia circolare, quel percorso virtuoso che riesce a trasformare uno scarto in risorsa. Per prima cosa i rifiuti: nel 2022 gli italiani hanno riciclato l’83% della totalità dei rifiuti, sia urbani cioè Stefania Fanucci Image by ...
In Italia è cresciuta in modo molto preoccupante la popolazione dei granchi blu fino a diventare un pericolo per l’ambiente e per gli animali che ci sono intorno. Il granchio blu ha trovato il modo di Stefania Fanucci Immagine da ...
Scoperte in un fiume cinese alcune formazioni rocciose che con un processo chimico ancora da studiare inglobano sacchetti e reti. Sarà la natura del futuro? Dove si trova la plastica? La plastica si trova nel sottosuolo, nelle profondità del mare, ...
Nel mese di marzo (il 3) si è celebrata la giornata internazionale della Natura Selvatica. Cosa significa natura selvatica? Le piante che nascono e si sviluppano senza l’opera dell’uomo e gli animali che vivono in libertà in un ambiente non ...
Grande come Londra (Inghilterra) un iceberg gigantesco si è staccato dai ghiacci dell’Antartide (luogo che non appartiene a nessun stato è il continente circostante il Polo sud) e sta fluttuando verso ovest. È successo vicino alla Immagine di kjpargeter su ...
L’Unione Europea invita tutti i Paesi europei ad usare le alghe perché sono una grande risorsa per il nostro pianeta. Ti sarà capitato mentre nuotavi nell’acqua di veder galleggiare le alghe e magari toccarle con i piedi! Non è strano perché ...
Da pochi giorni si è conclusa in Egitto la Cop 27, una conferenza organizzata dalle Nazioni Unite sui cambiamenti climatici. Chi ha partecipato alla Cop 27? I potenti del Pianeta cioè i capi di quasi 200 paesi del mondo il ...